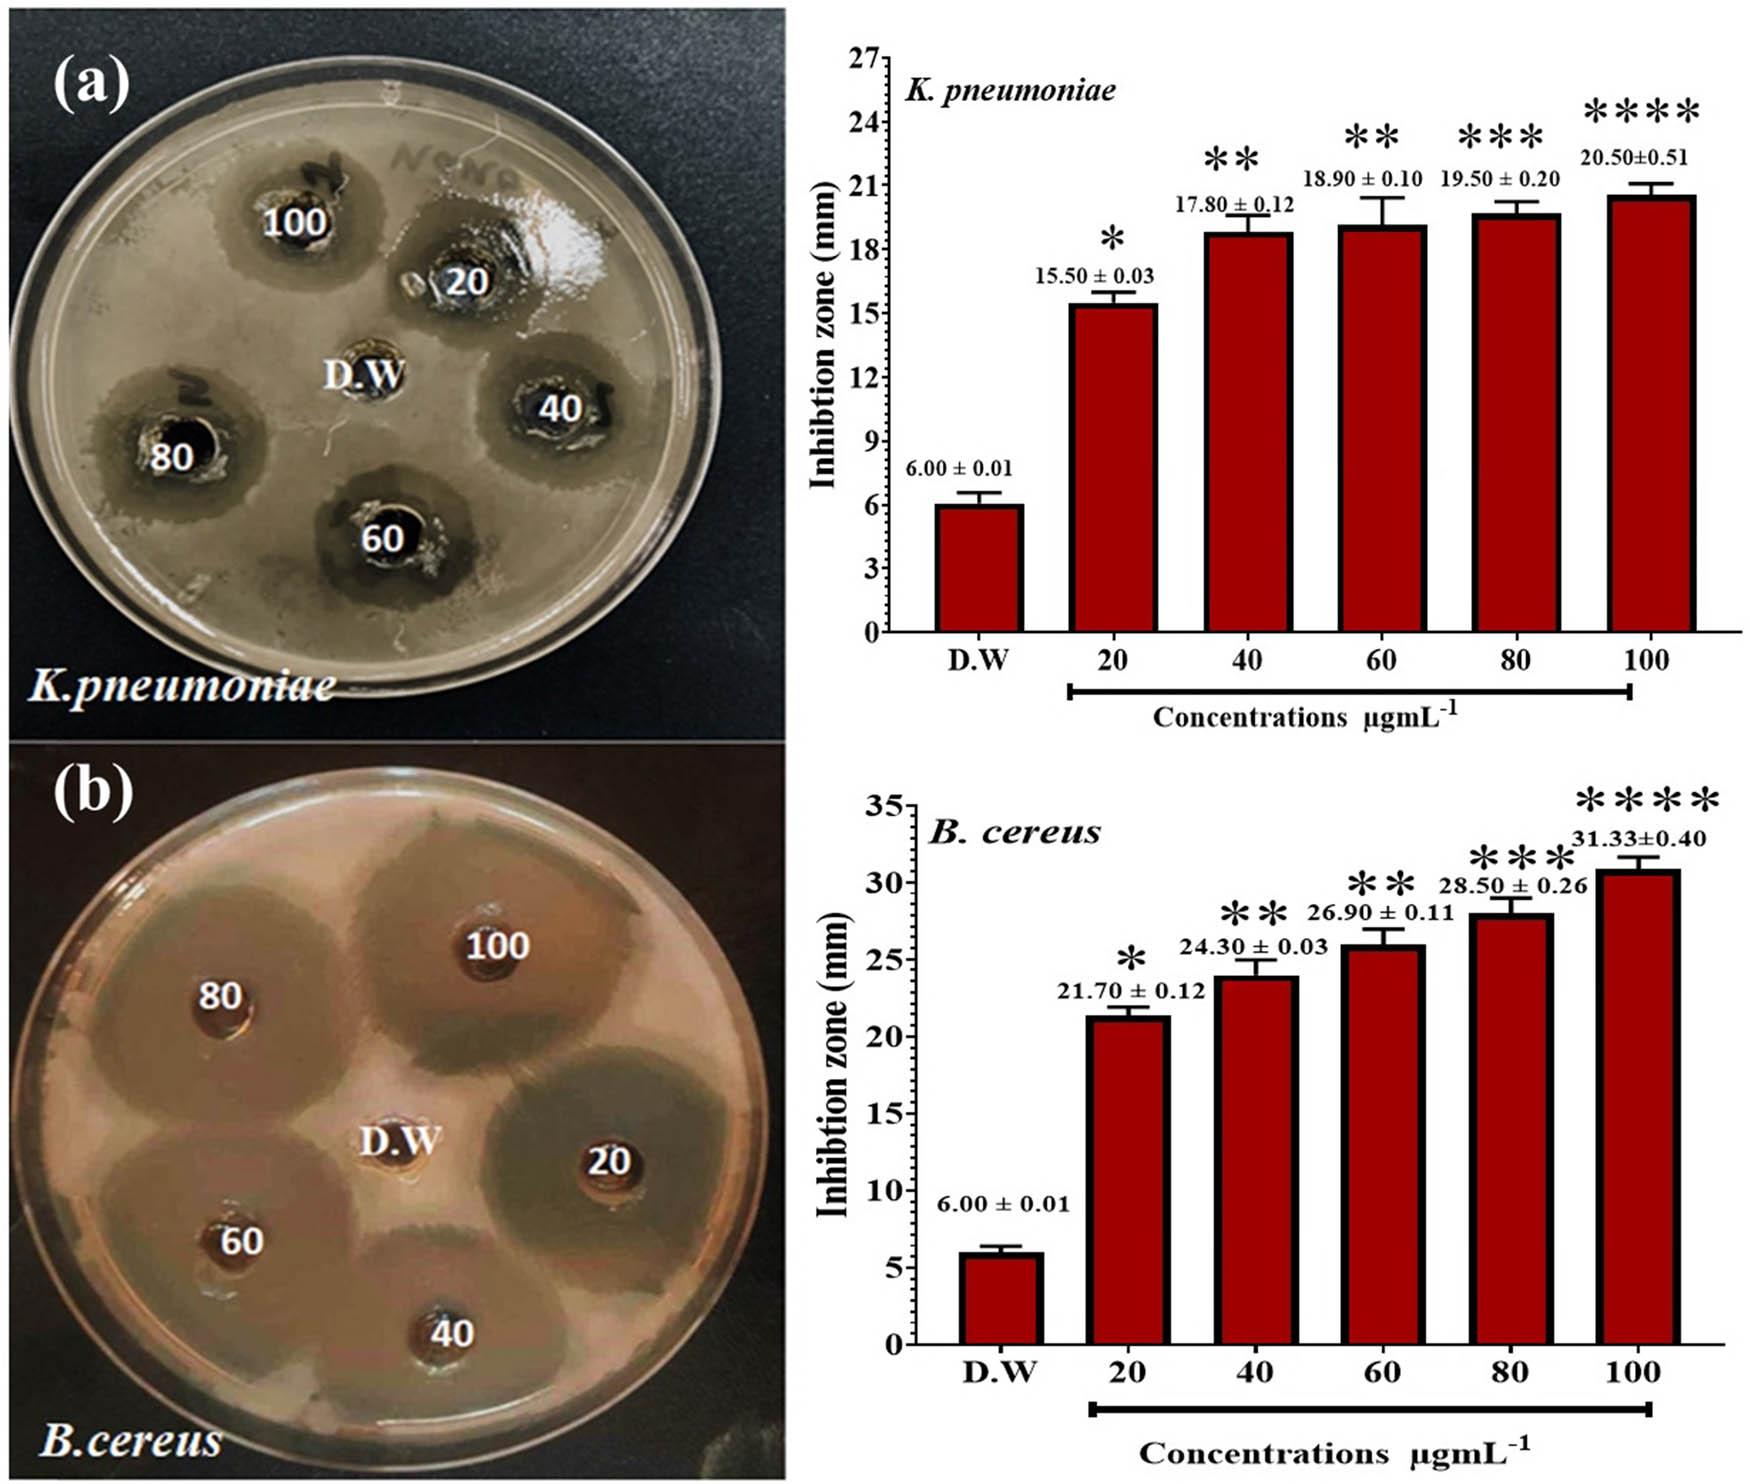

Green synthesis of parsley-derived silver nanoparticles and their enhanced antimicrobial and antioxidant effects against foodborne resistant bacteria
-
Erieg Abdulwahab Mohamed
, Kareem Hussein Jawad
Abstract
Despite antibiotics’ effectiveness in treating infectious diseases, their misuse and overuse have led to a serious public health issue, known as antimicrobial resistance. This study addresses the growing public health challenge of antimicrobial resistance by presenting a novel approach for synthesizing silver nanoparticles (AgNPs) from parsley (Petroselinum crispum) leaves using an eco-friendly method. The study evaluated and compared the antibacterial properties of the prepared AgNPs and the parsley boiled leaf extract against two foodborne and resistant microbes, Bacillus cereus (B. cereus) and Klebsiella pneumoniae (K. pneumoniae). Characterization techniques, including UV-Vis spectrophotometry (UV-Vis), Fourier transform infrared spectroscopy, transmission electron microscopy, X-ray diffraction, and energy dispersive X-ray spectroscopy, confirmed the successful synthesis of spherical nanoparticles with crystalline structure at the nanoscale level. The boiled parsley leaf extract showed a lower antimicrobial effect compared to the nanosilver extract at the same concentration and against the same types of bacteria. The extract showed the highest inhibition zone against B. cereus and K. pneumoniae at 14.50 and 10.50 mm, respectively; however, AgNPs showed inhibition zones of 31.33 and 20.50 mm against the same bacteria, respectively. In addition, AgNPs exhibited strong antibacterial activity against B. cereus and K. pneumoniae, significantly outperforming ceftriaxone (P ≤ 0.05). Moreover, AgNPs are more effective than the traditional antibiotic ceftriaxone at preventing bacterial growth at a minimum inhibitory concentration of 32 μg·mL−1. Additionally, AgNPs scavenge DPPH free radicals at the maximum concentration at rates of 85.60% compared to 65.89%, demonstrating superior antioxidant activity than the parsley extract. According to the findings, parsley-derived AgNPs have the potential to be antibacterial agents, particularly against food-related bacteria that are resistant to antibiotics, and thus, present novel strategies for combating antibiotic resistance. These findings pave the way for innovative techniques in antimicrobial therapy.
1 Introduction
Nanotechnology is a rapidly growing field in materials science [1], focusing on the modification of matter at the nanoscale, resulting in unique chemical, physical, and biological properties [2–4]. Silver nanoparticles (AgNPs) are a unique nanomaterial with numerous applications in antimicrobial coatings, medical devices, and drug delivery systems, addressing urgent challenges in environmental sustainability, healthcare, and energy [5–8]. AgNPs, known for their anti-infective and optical properties, are gaining interest for their synthesis by environmentally friendly techniques using plant extracts as a sustainable substitute [9,10]. Furthermore, their optical properties make them valuable in sensing applications, and their conductivity finds use in electrical components [11,12]. As research on AgNPs has increased, they have been regarded as a versatile tool that could address problems ranging from healthcare to renewable energy solutions [13]. AgNPs have numerous applications in the fields of optoelectronics, antibiotics, catalysis, detection and diagnostics, and alternative therapies.
Several attempts to employ AgNPs for an anti-cancer treatment have yielded positive results. Nonetheless, the discovery that AgNPs have medicinal applications could pave the way for novel methods of drug development in the medical domain [14,15]. Several techniques are available to produce AgNPs, including thermal breakdown, photochemical methods, chemical reactions, reverse micelles, radiation-assisted processes, electrochemical methods, and, most recently, the green synthesis technique [16]. The biological method of producing nanoparticles using plants, plant extracts, enzymes, and microorganisms offers several advantages over chemical and physical methods [17].
Parsley (Petroselinum crispum), a versatile herb with numerous nutritional and pharmaceutical applications [18–20], is a popular choice in Mediterranean cuisine. Originating from the Mediterranean, it comes in curly-leafed and flat-leaf varieties. Its flavorful attributes, diuretic and anti-inflammatory properties, and abundant vitamins A, C, and K make it a versatile ingredient [21]. Parsley extracts have been found to be antioxidants, scavenging free radicals [22,23].
Bacillus cereus and K. pneumoniae are common foodborne pathogens known for their resistance to multiple antibiotics, posing significant challenges in clinical and food safety contexts. A frequent bacterium that causes foodborne illnesses is B. cereus, which secretes and creates a wide range of toxins that may harm human health and cause a multitude of illnesses, such as emetic syndrome and diarrhea. This results in diarrheal and emetic sickness, among other foodborne disorders [24]. Watery diarrhea and stomach pain are the main signs of the diarrheal type, which is usually linked to the infection with B. cereus cells that produce enterotoxins. Because of its high capacity for survival, B. cereus may last in various natural settings, such as soil and plants. The endospore promotes the development of biofilms and demonstrates tolerance to various stressors. Generally speaking, Bacillus species are resistant to sulfonamide, glycopeptide, and β-lactam antibiotics [25,26]. In addition to being a significant hospital-acquired infectious agent, K. pneumoniae is a significant foodborne bacterium that may cause diarrhea, liver abscess, and septicemia. K. pneumoniae is an important foodborne pathogen often discovered in a variety of foods, such as raw vegetables, powdered baby formula, meat, fish, and street foods [27]. Numerous virulence factors, including iron-scavenging systems, siderophores, endotoxins, adhesins, and capsules, are expressed by K. pneumoniae and have been shown to be essential to its pathogenesis. K. pneumoniae is also known to be resistant to carbapenems, monobactams, and cephalosporins [28].
Antimicrobial resistance is a growing public health concern, causing antibiotic abuse and overuse in agriculture and medicine. This resistance increases mortality rates, hospital stays, and medical expenses, necessitating innovative therapeutic approaches to counter this growing threat [27]. The purpose of this study is to synthesize AgNPs from parsley (Petroselinum crispum) leaves and assess their antioxidant and antibacterial capabilities against K. pneumoniae and B. cereus, two frequent foodborne pathogens. By examining this innovative use, we hope to improve food safety and aid in the creation of viable substitutes in the fight against antibiotic resistance.
2 Materials and methods
2.1 Materials
Mueller-Hinton agar (MHA), silver nitrate (AgNO3), and SDA (Oxoid) were purchased from Merck (Germany). Ceftriaxone was obtained from Pioneer DJ. All the organic solvents used were from the Sigma Chemical Co. Prof. Dr. Sakeena Abbas (Department of Plant, College of Biology Science, University of Baghdad/Iraq) identified the plant materials. The parsley leaf was purchased from a well-known local market in Baghdad, Iraq. The strains K. pneumoniae and B. cereus are maintained by the Department of Applied Sciences, University of Technology, Baghdad, Iraq.
2.2 Preparation of the extract
To prepare the parsley extract, 100 g of fresh parsley leaves (Petroselinum crispum) were thoroughly washed and then boiled in 300 mL of distilled water for 30 min. Subsequently, the extracts were filtered through filter paper and left to dry at room temperature. Then, the extract was stored for further use at 4°C in a refrigerator [29].
2.3 Preparation of AgNPs using parsley leaf extract
To synthesize AgNPs, 50 mL of a 5 mM silver nitrate (AgNO3) solution was mixed with 3 mL of parsley (P. crispum) leaf extract. The mixture was placed in a water bath maintained at 85°C and stirred using a magnetic stirrer for 45 min. Following the reaction, the mixture was centrifuged at 14,000 rpm for 20 min. The supernatant was discarded, and the resulting pellet was washed three times with distilled water. The washed pellet was dried in an oven at 65°C for 24 h. The dried AgNPs were stored in a desiccator for further analysis [29].
2.4 Characterization of AgNPs
A LAMBDA 365 spectrophotometer (PerkinElmer, Waltham, MA, USA) was used to capture the ultraviolet-visible (UV-Vis) spectrum at 200–800 nm. A powder X-ray diffraction (XRD) 2700AB diffractometer (HAOYUAN, Zhejiang, China) was used to perform XRD analysis. Fourier transform infrared spectroscopy (FT-IR, PerkinElmer, Waltham, MA, USA) was performed to determine the samples’ active groups between 4,000 and 500 cm−1. Microscopy of field-emission scanning electrons (FE-SEM): FEI, Eindhoven, Netherlands and Zeiss, Jena, Germany's transmission electron microscopy (TEM) were also used [30].
2.5 Antimicrobial assays
2.5.1 Minimum inhibitory concentration (MIC) analysis
This experiment aims to determine the MIC of ceftriaxone and AgNPs, using microdilution plates and evaluating turbidity to effectively stop B. cereus and K. pneumoniae growth [31].
2.5.2 Well diffusion method
The study evaluated the antibacterial properties of AgNPs and parsley extract on bacterial strain growth using MHA medium and bacterial suspensions. The McFarland standard was used to attain suspensions at 1.5 × 108 colony-forming units (CFU) mL−1. Each bacterial suspension was swabbed onto an MHA medium plate, and then six wells with a 6 mm diameter were punched out of each plate using a sterile well cutter [31]. For every studied bacterium, 50 µL of the parsley leaf extract and AgNPs were added to the wells. As a negative control, deionized water was utilized. The antibacterial activity of the parsley leaf extract and AgNPs was determined by measuring the inhibitory zones surrounding each well, to the nearest millimeter, following a 24-h incubation period at 37°C. The synergistic effects of ceftriaxone (a standard antibiotic) and AgNPs were estimated using well-diffusion agar, and ceftriaxone, an antibacterial agent, was used as a positive control. MHA was inoculated with bacteria, and 100 µL of AgNPs and ceftriaxone were added to the wells. After 24 h incubation at 37°C, the inhibition zone was observed. The zones of inhibition were measured in mm, and the experiment was run in triplicate [32].
2.6 Antioxidant activity
By using the free radical 2,2-diphenyl-1-picrylhydrazyl (DPPH), the radical scavenging assay was carried out. Parsley leaf extract and AgNPs were diluted in distilled water to the following concentrations: 20, 40, 60, 80, and 100 µg·mL−1. To prepare DPPH, 0.001 mg of the DPPH powder was dissolved in 100 mL of pure methanol. To prepare the standard ascorbic acid solution, 0.05 mg of the ascorbic acid was dissolved in 100 mL of an ethanol and water (1:1) mixture. A final volume of 2 mL was formed by mixing equal volumes (1,000 μL) from parsley leaf extract at different concentrations and AgNPs. After mixing the reaction mixture, it was incubated at room temperature in the dark for half an hour. At 517 nm, the absorbance (optical density, OD) was measured. The samples’ ability to block the DPPH radical was estimated using the following equation [30]:
2.7 Statistical analysis
GraphPad Prism (version 7) was used to analyze the data. Tukey’s post-hoc test was used after a one-way ANOVA to determine the significance of group differences. A significance level of p < 0.05 was established. The experiments were conducted in triplicate, and the results are presented as mean ± standard deviation (SD) [31]. The antimicrobial and antioxidant properties of the parsley-derived AgNPs were thoroughly assessed using this statistical method, which also ensured reliable data interpretation.
3 Results and discussion
3.1 Characterization of nanomaterials
Parsley leaf extract synthesis and characterization: AgNPs were synthesized using the green synthesis method, which involved combining the plant extract with silver nitrate. Biological reduction is one of the most widely used techniques for producing AgNPs because of its high yield, affordability, and ease of use [33]. Figure 1 illustrates the green production of AgNPs using 5 mM AgNO3. A fresh greenish-colored suspension of hot parsley aqueous extract was produced. However, the suspension turned rich dark green once AgNO3 was added. The mixture was stirred using a magnetic stirrer for 45 min at 85°C.

UV-vis spectra of the (a) plant extract and (b) AgNPs.
The production of AgNPs was confirmed by UV-Vis spectral analysis, and a silver surface plasmon resonance band appeared at 434 nm (Figure 1). The UV-Vis spectrum of the hot aqueous extract from celery was found at 352 nm. These outcomes were comparable to the results of Balachandran et al. [34].
FT-IR analysis was performed on the plant extract and AgNP samples. Transmittance maxima for AgNPs were observed at 3,600, 2,901.33, 2,003.41, 1,598.631, and 649.43 cm−1. As some O-H groups were inactive during the oxidation process and some moisture was adsorbed onto the highly reactive surface of AgNPs, the peak at 3,600 cm−1 was attributed to the O–H (hydroxyl group) [35], as shown in Figure 2a and b.

FTIR spectra of the (a) plant extract and (b) AgNPs.
In Figure 3, the XRD pattern of the biosynthesized AgNPs produced by the leaf extract was further evaluated and substantiated by the characteristic peaks observed. When compared with the Joint Committee on Powder Diffraction Standards (JCPDS File nos 04-0783 and 03-0921), the XRD pattern at 2Ɵ revealed Bragg reflections at 24.37°, 30.40°, 40.05°, 43.55°, and 64.50° corresponding to the (001), (101), (111), (200), (222), and (220) planes, respectively, in the range of 10–70, indicating a face-centered cubic (fcc) structure for AgNPs.

XRD patterns of AgNPs.
The TEM image of AgNPs was examined along with a histogram displaying the particle sizes obtained from a set of TEM images. Measurements were performed on 55 particles using the ImageJ program. These images were captured to study AgNPs prepared using a green synthesis method, which involved the combination of AgNPs and their bonding with ethanolic leaf extract. Figure 4 shows the TEM image of pure AgNPs in the form of an asymmetrical spherical particle. The mean size of AgNPs, as determined by a size distribution analysis, was approximately 22 nm.

TEM and particle distribution size for the synthesized AgNPs.
The energy dispersive X-ray (EDX) spectra of AgNPs reveal that the three primary elements are Ag, C, and O (Figure 5). Furthermore, the amount of Ag (silver) was highest at 69.2%, followed by C (carbon) at 20%, O (oxygen) at 18.3%, and K at 2%, as shown in Figure 5.

EDX analysis and elemental mapping for AgNPs. (a) EDX spectrum, (b) SEM image, (c) Ag, (d) carbon, (e) oxgen, and (f) potassium.
3.2 Antioxidant activity
We have used direct and indirect methods to assess the free radical scavenging of the plant extract and the prepared AgNPs. The method involves the use of the DPPH free radical, and its reduction in color was measured as an indicative of the antioxidant power of the samples [31]. AgNPs and aqueous hot extract were tested for their antioxidant properties by the DPPH free radical. The results of the assays for AgNPs and aqueous extract of the plant showed that the amount of DPPH scavenged matched the concentrations of the aqueous extract and AgNPs at 20, 40, 60, 80, and 100 μg·mL−1. The DPPH free radicals’ scavenging abilities were 36.09 ± 0.11, 41.02 ± 0.54, 45.11 ± 0.04, 55.50 ± 0.10, and 65.89 ± 0.01 for the plant extract, whereas those for AgNPs were 55.79 ± 0.01, 60.92 ± 0.04, 62.11 ± 1.04, 77.10 ± 0.02, and 85.60 ± 0.01, respectively (Figure 6). The standard antioxidant compound, ascorbic acid, exhibited better antioxidant activity compared to the plant extract at all tested concentrations. However, AgNPs showed comparable effects on ascorbic acid, especially at the highest two concentrations, i.e., 80 and 100 μg·mL−1. The aqueous extract of parsley as well as the other extracts of the plant have been reported for their potential antioxidant effect [36–38]. The study indicates that AgNPs enhance the antioxidant activity of the aqueous extract, making it a promising candidate for food preservation and health supplements.

Antioxidant activities of the plant extract, AgNPs, and ascorbic acid. *P ≤ 0.05, **P ≤ 0.01, ***P ≤ 0.001, and ****P ≤ 0.0001.
Food preservation and overall health depend on the antioxidant activity. By avoiding oxidative damage, rancidity, and rotting, antioxidants extend the shelf life of food while maintaining its nutritional value, flavor, and quality [20,37]. Furthermore, they possess antibacterial properties that enhance food safety by preventing the development of bacteria that cause spoiling [14]. By scavenging free radicals, antioxidants help prevent long-term conditions like cancer and heart disease [15]. Additionally, they strengthen the immune system and have anti-inflammatory properties, which promote general health [25]. Antioxidant-rich foods, such as fruits and vegetables, enhance the body’s ability to absorb other nutrients and supply necessary nutrients [37]. Therefore, promoting the consumption of foods high in antioxidants can improve food security and public health outcomes.
3.3 Antimicrobial evaluation
B. cereus, a common foodborne illness bacterium, produces a wide range of toxins that can harm humans and cause emetic syndrome and diarrhea. It causes diarrhea, emesis, and other foodborne illnesses [39,40]. B. cereus can survive in soil and plants due to its high survival rate [41,42]. The endospore promotes biofilms and is stress-tolerant. Bacillus species typically resist sulfonamides, glycopeptides, and β-lactam antibiotics [25,26]. In addition, the foodborne K. pneumoniae can also cause diarrhea, liver abscesses, and septicemia in addition to hospital-acquired diseases [43,44]. K. pneumoniae is found in raw vegetables, powdered baby formula, meat, fish, and street food. K. pneumoniae’s pathogenesis depends on its iron-scavenging systems, siderophores, endotoxins, adhesins, and capsules. K. pneumoniae resists carbapenems, monobactams, and cephalosporins [28].
We have evaluated the parsley extract and the parsley-based prepared AgNPs against both microorganisms. Table 1 shows the results of the varying effects of the aqueous extract of parsley leaf on the growth of the isolated bacteria tested. The highest inhibition zone of the hot leaf extract was on B. cereus. Table 2 shows the results of the effects of nanoextracts on the growth of bacteria tested, and shows a higher effect than the ethanolic extract. The highest inhibition zone was on K. pneumoniae (20.50 ± 0.51 mm) and B. cereus (31.33 ± 0.40 mm). The study with distilled water shows no zone of inhibition against the bacteria, as shown in Figures 7 and 8. Therefore, in this investigation, it was noticed that the AgNPs synthesized by the aqueous extract of parsley exerted a significant antibacterial action against the tested bacteria. The zone of inhibition against tested bacteria for AgNPs was 25.50 mm, which shows excellent antibacterial activity with a large zone of inhibition. Nanomaterials like AgNPs have been extensively studied for their ability to combat bacteria by inhibiting their growth and survival [30,45]. The mechanism of action involves several factors: physical communication, silver ions, and oxygen species (ROS) release and breakdown of biofilms. Frequently, bacteria produce biofilms. Biofilms offer defense and strengthen resistance to traditional antimicrobial agents [46].
Antibacterial activity of the parsley extract against K. pneumonia and B. cereus
| Microorganisms | Inhibition zone of the extract plant (mm) ± SD (concentration, µg·mL−1) | |||||
|---|---|---|---|---|---|---|
| Negative control (D.W.) | 20 | 40 | 60 | 80 | 100 | |
| K. pneumoniae | 6.00 ± 0.01 | 6.30 ± 0.12 | 6.70 ± 0.30 | 9.60 ± 0.10 | 9.70 ± 0.21 | 10.50 ± 0.20 |
| B. cereus | 6.00 ± 0.01 | 7.00 ± 0.12 | 8.20 ± 0.03 | 9.80 ± 0.22 | 12.50 ± 0.01 | 14.50 ± 0.33 |
Antibacterial action of AgNPs against K. pneumonia and B. cereus
| Microorganisms | Inhibition zone of AgNPs (mm) ± SD (concentration, µg·mL−1) | |||||
|---|---|---|---|---|---|---|
| Negative control (D.W.) | 20 | 40 | 60 | 80 | 100 | |
| K. pneumoniae | 6.00 ± 0.01 | 15.50 ± 0.03 | 17.80 ± 0.12 | 18.90 ± 0.10 | 19.50 ± 0.20 | 20.50 ± 0.51 |
| B. cereus | 6.00 ± 0.01 | 21.70 ± 0.12 | 24.30 ± 0.03 | 26.90 ± 0.11 | 28.50 ± 0.26 | 31.33 ± 0.40 |

Antibacterial action of the extract against (a) K. pneumonia and (b) B. cereus. Deionized distilled water (D.W.) was used as a negative control. *P ≤ 0.05, **P ≤ 0.01, and ***P ≤ 0.001.
Antibacterial action of AgNPs against (a) K. pneumonia and (b) B. cereus. Deionized distilled water (D.W.) was used as a negative control. *P ≤ 0.05, **P ≤ 0.01, ***P ≤ 0.001, and ****P ≤ 0.0001.
Biofilms can be broken up by nanomaterials, such as AgNPs, which can penetrate the matrix, prevent bacteria from adhering, and cause the biofilm’s structure to become unstable. This possible alteration suggests that there is an attraction between the virus and NPs. The bacterial cell membrane becomes positive as a result of the exterior envelope’s reaction to the stress it has caused. The NPs can combine with the bacteria’s surface if they are directed above minimum levels, which can cause a charge change [31,32,47–49]. Although the exact mode of action of AgNPs against all bacteria is unknown, it appears that the nanoparticles exhibit antibacterial activity by interfering with the respiratory metabolism of the bacteria, as shown in Figures 7 and 8 and Tables 1 and 2.
3.3.1 Synergistic effect
In addition to the results for the parsley-derived AgNPs and parsley extract, the antibacterial activity of the standard antibiotic, ceftriaxone, was also evaluated. Table 3 provides a summary of the findings.
Synergistic effects of AgNPs and ceftriaxone
| Mean ± SD (mm) | |||||
|---|---|---|---|---|---|
| Microorgansims | AgNPs only | Positive control (ceftriaxone) | (AgNPs) + ceftriaxone | Negative control (D.W.) | P-value |
| K. pneumoniae | 19.06 ± 0.12a | 20.73 ± 0.40b | 30.73 ± 0.10c | 6.00 ± 0.01 | 0.000 |
| B. cereus | 24.06 ± 0.11a | 23.25 ± 0.19b | 35.25 ± 0.35d | 6.00 ± 0.01 | 0.000 |
Note: Values sharing the same letter in a row are deemed not statistically significant, while those with different letters indicate a significant difference.
Since both K. pneumoniae and B. cereus displayed larger inhibition zones when paired with ceftriaxone, the data suggest that using AgNPs alone increases the effectiveness of the antibiotics. In comparison to AgNPs alone (19.06 ± 0.12 mm) and ceftriaxone alone (20.73 ± 0.40), the efficacy of AgNPs + ceftriaxone (30.73 ± 0.10 mm) against K. pneumoniae was significantly higher. In contrast to AgNPs alone (24.06 ± 0.11 mm) and ceftriaxone alone (23.25 ± 0.19 mm), the results were better with AgNPs + ceftriaxone (35.25 ± 0.35 mm) for B. cereus. A substantial statistical difference is shown by values with distinct letters, but values with the same letter in a row are regarded as statistically non-significant. According to the findings, AgNPs increase ceftriaxone’s efficacy against the bacteria under study, creating new opportunities for the development of better treatment approaches to treat bacterial illnesses. The study found that AgNPs and ceftriaxone can disrupt the activity of topoisomerase IV and DNA gyrase, leading to bacterial cell death. AgNPs, with their unique properties and low cytotoxicity, have the potential to treat bacterial infections due to their ability to enhance membrane permeability and induce cell death [31,50].
AgNPs effectively combat bacteria by causing structural damage and oxidative stress, leading to cell death through the generation of reactive oxygen species. AgNPs disrupt metabolic pathways, impacting energy production and cellular functions. They also destabilize biofilms, enhancing antibacterial therapies against resistant bacteria. However, little is known about the precise ways in which AgNPs interact with bacterial constituents like proteins, lipids, and nucleic acids [51,52]. Further research is also required to determine how the size, shape, surface charge, and coating of nanoparticles affect their antibacterial activity [53].
The green synthesis of AgNPs depends on the phytochemicals found in parsley, such as flavonoids, phenolic compounds, vitamins, and essential oils [18]. By neutralizing silver ions and stopping their oxidation, nanoparticles’ antioxidant qualities aid in the reduction process [19]. As capping agents, the phytochemicals in parsley keep AgNPs from clumping, ensure stability, improve their antibacterial qualities, and maintain biological activity over time. The reactivity and efficacy of AgNPs as antimicrobials are affected by their size and shape, which are determined by the type and concentration of phytochemicals; smaller particles exhibit higher reactivity [29].
AgNPs made from parsley (P. crispum) exhibit outstanding antibacterial properties against B. cereus and K. pneumoniae, according to this study, which compares and contrasts its findings with earlier research on parsley-based AgNPs. This study supports earlier discoveries that AgNPs are potent antibacterial agents that can treat a range of illnesses [14,15]. AgNPs enhanced antibacterial activity in combination with traditional antibiotics like ceftriaxone, supporting the idea that nanoparticles can enhance the efficacy of existing antibiotics, potentially combating antibiotic resistance [54]. The green synthesis of AgNPs using parsley extracts offers a sustainable, less hazardous alternative to traditional chemical methods, utilizing the inherent qualities of plant materials, suggesting that the manufacturing method may have an impact on the efficacy of the final nanoparticles [29]. Nonetheless, the study demonstrates that AgNPs have stronger antibacterial activity than the boiling parsley leaf extract at equivalent doses. This contrasts with other previous studies that revealed identical antibacterial activities between plant extracts and the nanoparticles they generated, suggesting that the synthesis process may affect the efficacy of the final nanoparticles [12,55,56]. This study utilized various characterization methods, including UV-Vis spectroscopy, FTIR, TEM, XRD, and EDX, to comprehensively understand the structural characteristics of AgNPs, surpassing previous research’s limitations [56]. AgNPs demonstrated superior antioxidant activity compared to parsley extract, highlighting their enhanced ability to scavenge free radicals, a finding that has not been previously compared [37,55]. This study found an MIC of 32 μg·mL−1 for AgNPs, indicating varying efficacy across different research contexts due to varying microbial strains and synthesis methods [57].
4 Conclusions
This study used an environmentally friendly green synthesis method to successfully produce AgNPs from parsley (P. crispum) leaves. The spherical form and crystalline structure of the nanoparticles were confirmed through characterization methods such as UV-Vis and FTIR spectroscopy, TEM, XRD, and EDX. The AgNPs showed potent antibacterial activity against K. pneumoniae, B. cereus, and resistant and foodborne bacteria. At an MIC of 32 μg·mL−1, AgNPs outperformed ceftriaxone in terms of antibacterial activity. When compared to the boiled leaf extract alone, the antioxidant properties of conjugated AgNPs were enhanced. Future research should investigate the safety and efficacy of AgNPs in vivo using various animal models, including mice and rats, to understand their pharmacokinetics, biodistribution, and potential toxicological effects. Long-term studies are needed to evaluate toxicity, chronic exposure, and biological effectiveness of AgNPs, including antibacterial and antioxidant efficacy against resistant strains, and immune system interactions. Optimizing AgNP synthesis involves analyzing reaction parameters, modifying silver nitrate and plant extract concentrations, and examining capping agents. Real-world applications require scalability and high-quality large-scale synthesis methods. Advanced methods like molecular imaging, proteomics, and genomics, combined with sophisticated characterization techniques, will enhance our understanding of the pharmacokinetics, safety profiles, and therapeutic potential of AgNPs.
Acknowledgments
The authors are thankful to the Deanship of Graduate Studies and Scientific Research at the University of Bisha for supporting this work through the Fast-Track Research Support Program.
-
Funding information: Authors state no funding involved.
-
Author contributions: conceptualization and methodology: E.A.M., B.A.H., and N.I.A.; formal analysis: B.A.H. and E.A.M.; investigation and data curation: M.M.A., G.M.S., and B.A.H.; validation: E.A.M. and B.A.H.; visualization and original draft preparation: G.M.S. and B.A.H.; writing – review and editing: M.M.A., B.A.H., G.M.S., K.H.J., H.A.S.A., and H.A.M.; supervision: B.A.H. and G.M.S. All authors have read and agreed to the published version of the manuscript.
-
Conflict of interest: The authors state no conflicts of interest.
-
Data availability statement: The datasets generated during and/or analyzed during the current study are available from the corresponding author on reasonable request.
References
[1] Manoharan M. Research on the frontiers of materials science: The impact of nanotechnology on new material development. Technol Soc. 2008;30(3–4):401–4.10.1016/j.techsoc.2008.04.016Suche in Google Scholar
[2] Pawar S. Science of nanomaterials. Prog Prospect Nanosci Today. 2020;1:1–414.Suche in Google Scholar
[3] Abdellatif AAH, Mohammed HA, Khan RA, Singh V, Bouazzaoui A, Yusuf M, et al. Nanoscale delivery: A comprehensive review of nano-structured devices, preparative techniques, site-specificity designs, biomedical applications, commercial products, and references to safety, cellular uptake, and organ toxicity. Nanotechnol Rev. 2021;10(1):1493–559.10.1515/ntrev-2021-0096Suche in Google Scholar
[4] Tawiah B, Ofori EA, George SC. Nanotechnology in societal development. In Nanotechnology in societal development. Singapore: Springer; 2024. p. 1–64.10.1007/978-981-97-6184-5_1Suche in Google Scholar
[5] Ikumapayi OM, Laseinde OT. Nanomanufacturing in the 21st century: a review of advancements, applications and future prospects. J Européen des Systèmes Automatisés. 2024;57(4):1235–48.10.18280/jesa.570430Suche in Google Scholar
[6] Khane Y, Albukhaty S, Sulaiman GM, Fennich F, Bensalah B, Hafsi Z, et al. Fabrication, characterization and application of biocompatible nanocomposites: a review. Eur Polym J. 2024;214:113187.10.1016/j.eurpolymj.2024.113187Suche in Google Scholar
[7] Ramsden J. Applied nanotechnology: the conversion of research results to products. United Kingdom: William Andrew; 2018.Suche in Google Scholar
[8] Verma RK, Kesarwani S, Xu J, Davim JP. Polymer nanocomposites: Fabrication to applications. USA: CRC Press; 2023.10.1201/9781003343912Suche in Google Scholar
[9] Hsu C-Y, Rheima AM, Kadhim MM, Ahmed NN, Mohammed SH, Abbas FH, et al. An overview of nanoparticles in drug delivery: Properties and applications. South Afr J Chem Eng. 2023;46:233–70. 10.1016/j.sajce.2023.08.009.Suche in Google Scholar
[10] Xu L, Yi-Yi W, Huang J, Chun-Yuan C, Zhen-Xing W, Xie H. Silver nanoparticles: Synthesis, medical applications and biosafety. Theranostics. 2020;10(20):8996.10.7150/thno.45413Suche in Google Scholar PubMed PubMed Central
[11] Aouf D, Khane Y, Fenniche F, Albukhaty S, Sulaiman GM, Khane S, et al. Biogenic silver nanoparticles of Moringa oleifera leaf extract: Characterization and photocatalytic application. Nanotechnol Rev. 2024;13(1):20240002.10.1515/ntrev-2024-0002Suche in Google Scholar
[12] Natsuki J, Natsuki T, Hashimoto Y. A review of silver nanoparticles: synthesis methods, properties and applications. Int J Mater Sci Appl. 2015;4(5):325–32.10.11648/j.ijmsa.20150405.17Suche in Google Scholar
[13] Madani M, Hosny S, Alshangiti DM, Nady N, Alkhursani SA, Alkhaldi H, et al. Green synthesis of nanoparticles for varied applications: Green renewable resources and energy-efficient synthetic routes. Nanotechnol Rev. 2022;11(1):731–59.10.1515/ntrev-2022-0034Suche in Google Scholar
[14] Bawazeer S. Green synthesis of silver nanoparticles from Euphorbia milii plant extract for enhanced antibacterial and enzyme inhibition effects. Int J Health Sci. 2024;18(2):25.Suche in Google Scholar
[15] Wei L, Lu J, Xu H, Patel A, Chen Z-S, Chen G. Silver nanoparticles: synthesis, properties, and therapeutic applications. Drug Discovery Today. 2015;20(5):595–601. 10.1016/j.drudis.2014.11.014.Suche in Google Scholar PubMed PubMed Central
[16] Schneidewind H, Schüler T, Strelau KK, Weber K, Cialla D, Diegel M, et al. The morphology of silver nanoparticles prepared by enzyme-induced reduction. Beilstein J Nanotechnol. 2012;3(1):404–14.10.3762/bjnano.3.47Suche in Google Scholar PubMed PubMed Central
[17] Das RK, Pachapur VL, Lonappan L, Naghdi M, Pulicharla R, Maiti S, et al. Biological synthesis of metallic nanoparticles: plants, animals and microbial aspects. Nanotechnol Environ Eng. 2017;2:1–21.10.1007/s41204-017-0029-4Suche in Google Scholar
[18] Ahmed WE, Almutairi AA, Almujaydil MS, Algonaiman R, Mousa HM, Alhomaid RM. Nutraceutical potential of parsley (Petroselinum crispum Mill.): Comprehensive overview. Italian J Food Science/Rivista Ital di Scienza degli Alimenti. 2025;37(1):194–209.10.15586/ijfs.v37i1.2806Suche in Google Scholar
[19] Wong PYY, Kitts DD. Studies on the dual antioxidant and antibacterial properties of parsley (Petroselinum crispum) and cilantro (Coriandrum sativum) extracts. Food Chem. 2006;97(3):505–15. 10.1016/j.foodchem.2005.05.031.Suche in Google Scholar
[20] Mahmood S, Hussain S, Malik F. Critique of medicinal conspicuousness of Parsley (Petroselinum crispum): a culinary herb of Mediterranean region. Pak J Pharm Sci. 2014;27(1):193–202.Suche in Google Scholar
[21] Sarwar S, Ayyub MA, Rezgui M, Nisar S, Jilani MI. Parsley: A review of habitat, phytochemistry, ethnopharmacology and biological activities. Int J Chem Biochem Sci. 2019;9:49–55.Suche in Google Scholar
[22] Ganea M, Vicaș LG, Gligor O, Sarac I, Onisan E, Nagy C, et al. Exploring the therapeutic efficacy of parsley (Petroselinum crispum mill.) as a functional food: Implications in immunological tolerability, reduction of muscle cramps, and treatment of dermatitis. Molecules. 2024;29(3):608.10.3390/molecules29030608Suche in Google Scholar PubMed PubMed Central
[23] Awulachew MT. The possible use of herbs and spices in the food processing and food safety. In Herbs and spices-new perspectives in human health and food industry. London: IntechOpen; 2024.Suche in Google Scholar
[24] Cha X, Lin Y, Brennan C, Cao J, Shang Y. Antibiotic resistance of Bacillus cereus in plant foods and edible wild mushrooms in a province. Microorganisms. 2023;11(12):2948. 10.3390/microorganisms11122948.Suche in Google Scholar PubMed PubMed Central
[25] Haque MA, Hu H, Liu J, Islam MA, Hossen F, Rahman MA, et al. Emergence of multidrug-resistant Bacillus spp. derived from animal feed, food and human diarrhea in South-Eastern Bangladesh. BMC Microbiology. 2024;24(1):61.10.1186/s12866-024-03199-3Suche in Google Scholar PubMed PubMed Central
[26] Chen J, Zhang J, Zhan L, Chen H, Zhang Z, Huang C, et al. Prevalence and antimicrobial-resistant characterization of Bacillus cereus isolated from ready-to-eat rice products in Eastern China. Front Microbiology. 2022;13:964823. 10.3389/fmicb.2022.964823.Suche in Google Scholar PubMed PubMed Central
[27] Zhuang HH, Chen QH, Wang W, Qu Q, Xu WX, Hu Q, et al. The efficacy of polymyxin B in treating stroke-associated pneumonia with carbapenem-resistant Gram-negative bacteria infections: a multicenter real-world study using propensity score matching. Front Pharmacology. 2025;16:1413563.10.3389/fphar.2025.1413563Suche in Google Scholar PubMed PubMed Central
[28] Zhou Y, Li L, Yu Z, Gu X, Pan R, Li Q, et al. Dermatophagoides pteronyssinus allergen Der p 22: Cloning, expression, IgE‐binding in asthmatic children, and immunogenicity. Pediatric Allergy Immunology. 2022;33(8):e13835.10.1111/pai.13835Suche in Google Scholar PubMed
[29] Ahmed ME, Sulaiman GM, Hasoon BA, Khan RA, Mohammed HA. Green synthesis and characterization of apple peel‐derived selenium nanoparticles for anti‐fungal activity and effects of MexA gene expression on efflux pumps in Acinetobacter baumannii. Appl Organomet Chem. 2025;39(2):e7805.10.1002/aoc.7805Suche in Google Scholar
[30] Ibraheem DR, Hussein NN, Sulaiman GM, Mohammed HA, Khan RA, Al Rugaie O. Ciprofloxacin-loaded silver nanoparticles as potent nano-antibiotics against resistant pathogenic bacteria. Nanomaterials. 2022;12(16):2808. 10.3390/nano12162808.Suche in Google Scholar PubMed PubMed Central
[31] Jawad KH, Jamagh FK, Sulaiman GM, Hasoon BA, Albukhaty S, Mohammed HA, et al. Antibacterial and antibiofilm activities of amikacin-conjugated gold Nanoparticles: A promising formulation for contact lens preservation. Inorg Chem Commun. 2024;162:112286.10.1016/j.inoche.2024.112286Suche in Google Scholar
[32] Mahdi LH, Hasoon BA, Sulaiman GM, Mohammed HA, Jawad KH, Al-Dulimi AG, et al. Anti-microbial efficacy of l-glutaminase (EC 3.5. 1.2) against multidrug-resistant Pseudomonas aeruginosa infection. J Antibiotics. 2024;77(2):111–9.10.1038/s41429-023-00678-zSuche in Google Scholar PubMed
[33] Meher A, Tandi A, Moharana S, Chakroborty S, Mohapatra SS, Mondal A, et al. Silver nanoparticle for biomedical applications: A review. Hybrid Adv. 2024;6:100184.10.1016/j.hybadv.2024.100184Suche in Google Scholar
[34] Balachandran YL, Girija S, Selvakumar R, Tongpim S, Gutleb AC, Suriyanarayanan S. Differently environment stable bio-silver nanoparticles: study on their optical enhancing and antibacterial properties. PLoS One. 2013;8(10):e77043.10.1371/journal.pone.0077043Suche in Google Scholar PubMed PubMed Central
[35] Tavassoli S, Cheraghi S, Etemadifar P, Mollahosseini A, Joodaki S, Sedighi N. Optimization and characterization of silver nanoparticle-modified luffa for the adsorption of ketoprofen and reactive yellow 15 from aqueous solutions. Sci Rep. 2024;14(1):4398.10.1038/s41598-024-54790-7Suche in Google Scholar PubMed PubMed Central
[36] de Menezes Epifanio NM, Cavalcanti LRI, Dos Santos KF, Duarte PSC, Kachlicki P, Ożarowski M, et al. Chemical characterization and in vivo antioxidant activity of parsley (Petroselinum crispum) aqueous extract. Food Funct. 2020;11(6):5346–56.10.1039/D0FO00484GSuche in Google Scholar
[37] Dorman HJD, Lantto TA, Raasmaja A, Hiltunen R. Antioxidant, pro-oxidant and cytotoxic properties of parsley. Food Funct. 2011;2(6):328–37.10.1039/c1fo10027kSuche in Google Scholar PubMed
[38] Park RJ, Ryu MJ, Park RJ, Ryu MJ. Antioxidant and antimicrobial effect of rosemary, parsley, thyme, chive, and dill extracts. Asian J Beauty Cosmetology. 2022;20(3):305–14.10.20402/ajbc.2022.0020Suche in Google Scholar
[39] Marrollo R. Bacillus cereus food-borne disease. In The diverse faces of Bacillus cereus. London: Elsevier; 2016. p. 61–72.10.1016/B978-0-12-801474-5.00005-0Suche in Google Scholar
[40] Haque MA, Quan H, Zuo Z, Khan A, Siddique N, He C. Pathogenicity of feed-borne Bacillus cereus and its implication on food safety. Agrobiological Rec. 2021;3:1–16.10.47278/journal.abr/2020.015Suche in Google Scholar
[41] West AW, Burges H, Dixon TJ, Wyborn CH. Survival of Bacillus thuringiensis and Bacillus cereus spore inocula in soil: effects of pH, moisture, nutrient availability and indigenous microorganisms. Soil Biol Biochem. 1985;17(5):657–65.10.1016/0038-0717(85)90043-4Suche in Google Scholar
[42] Berthold-Pluta A, Pluta A, Garbowska M. The effect of selected factors on the survival of Bacillus cereus in the human gastrointestinal tract. Microb Pathogenesis. 2015;82:7–14.10.1016/j.micpath.2015.03.015Suche in Google Scholar PubMed
[43] Hu Y, Anes J, Devineau S, Fanning S. Klebsiella pneumoniae: prevalence, reservoirs, antimicrobial resistance, pathogenicity, and infection: a hitherto unrecognized zoonotic bacterium. Foodborne Pathog Dis. 2021;18(2):63–84.10.1089/fpd.2020.2847Suche in Google Scholar PubMed
[44] Sahu MK, George N, Rastogi N, Bipin C, Singh SP. Uncommon pathogens causing hospital-acquired infections in postoperative cardiac surgical patients. J Card Crit Care TSS Vol. 2020;3(2):89–96.10.1055/s-0040-1705080Suche in Google Scholar
[45] Kanwal M, Sher M, Abbas A, Akhtar S, Siddique AB, Ul Hasan MN, et al. Dual colorimetric sensing of Hg (II) and Fe (III) using sulfanilamide-stabilized silver nanoparticles and evaluating their photodegradation and antibacterial properties. J Water Process Eng. 2025;75:107981.10.1016/j.jwpe.2025.107981Suche in Google Scholar
[46] Mahmood MA. The antibacterial effect of silver nanoparticles on some bacterial pathogens. Iraqi J Phys. 2012;10(18):56–61.Suche in Google Scholar
[47] Siddique AB, Amr D, Abbas A, Zohra L, Irfan MI, Alhoshani A, et al. Synthesis of hydroxyethylcellulose phthalate-modified silver nanoparticles and their multifunctional applications as an efficient antibacterial, photocatalytic and mercury-selective sensing agent. Int J Biol Macromolecules. 2024;256:128009.10.1016/j.ijbiomac.2023.128009Suche in Google Scholar PubMed
[48] Miller KP, Wang L, Benicewicz BC, Decho AW. Inorganic nanoparticles engineered to attack bacteria. Chem Soc Rev. 2015;44(21):7787–807.10.1039/C5CS00041FSuche in Google Scholar
[49] Luan Y, Liu S, Pihl M, van der Mei HC, Liu J, Hizal F, et al. Bacterial interactions with nanostructured surfaces. Curr OpColloid Interface Sci. 2018;38:170–89.10.1016/j.cocis.2018.10.007Suche in Google Scholar
[50] Zhang Y, Liu X, Luo J, Liu H, Li Y, Liu J, et al. Dual recombinase polymerase amplification system combined with lateral flow immunoassay for simultaneous detection of Staphylococcus aureus and Vibrio parahaemolyticus. J Pharm Biomed Anal. 2025;255:116621.10.1016/j.jpba.2024.116621Suche in Google Scholar PubMed
[51] Dakal TC, Kumar A, Majumdar RS, Yadav V. Mechanistic basis of antimicrobial actions of silver nanoparticles. Front Microbiol. 2016;7:1831.10.3389/fmicb.2016.01831Suche in Google Scholar PubMed PubMed Central
[52] Siddique AB, Shaheen MA, Abbas A, Zaman Y, Amin HM, Alam MM, et al. Sunlight-assisted greenly synthesised silver nanoparticles for highly selective mercury ion sensing, biomedical and photocatalytic applications. Int J Environ Anal Chem. 2025;1–23. 10.1080/03067319.2025.2502605.Suche in Google Scholar
[53] Kaweeteerawat C, Na Ubol P, Sangmuang S, Aueviriyavit S, Maniratanachote R. Mechanisms of antibiotic resistance in bacteria mediated by silver nanoparticles. J Toxicol Environ Health Part A. 2017;80(23–24);1276–89.10.1080/15287394.2017.1376727Suche in Google Scholar PubMed
[54] Casals E, Gusta MF, Bastus N, Rello J, Puntes V. Silver nanoparticles and antibiotics: a promising synergistic approach to multidrug-resistant infections. Microorganisms. 2025;13(4):952.10.3390/microorganisms13040952Suche in Google Scholar PubMed PubMed Central
[55] Sharifi-Rad M, Mohanta YK, Pohl P, Nayak D, Messaoudi M. Facile phytosynthesis of gold nanoparticles using Nepeta bodeana Bunge: Evaluation of its therapeutics and potential catalytic activities. J Photochem Photobiol A: Chem. 2024;446:115150.10.1016/j.jphotochem.2023.115150Suche in Google Scholar
[56] Khalid Z, Ali A, Siddique AB, Zaman Y, Sibtain MF, Abbas A, et al. Causonis trifolia-based green synthesis of multifunctional silver nanoparticles for dual sensing of mercury and ferric ions, photocatalysis, and biomedical applications. RSC Adv. 2025;15(21):16879–93.10.1039/D5RA01882JSuche in Google Scholar PubMed PubMed Central
[57] Jabbar A, Abbas A, Assad N, Naeem-ul-Hassan M, Alhazmi HA, Najmi A, et al. A highly selective Hg2+ colorimetric sensor and antimicrobial agent based on green synthesized silver nanoparticles using Equisetum diffusum extract. RSC Adv. 2023;13(41):28666–75.10.1039/D3RA05070JSuche in Google Scholar
© 2025 the author(s), published by De Gruyter
This work is licensed under the Creative Commons Attribution 4.0 International License.
Artikel in diesem Heft
- Research Articles
- Optimized green synthesis of silver nanoparticles from guarana seed skin extract with antibacterial potential
- Green adsorbents for water remediation: Removal of Cr(vi) and Ni(ii) using Prosopis glandulosa sawdust and biochar
- Green approach for the synthesis of zinc oxide nanoparticles from methanolic stem extract of Andrographis paniculata and evaluation of antidiabetic activity: In silico GSK-3β analysis
- Development of a green and rapid ethanol-based HPLC assay for aspirin tablets and feasibility evaluation of domestically produced bioethanol in Thailand as a sustainable mobile phase
- A facile biodegradation of polystyrene microplastic by Bacillus subtilis
- Enhanced synthesis of fly ash-derived hydrated sodium silicate adsorbents via low-temperature alkaline hydrothermal treatment for advanced environmental applications
- Impact of metal nanoparticles biosynthesized using camel milk on bacterial growth and copper removal from wastewater
- Preparation of Co/Cr-MOFs for efficient removal of fleroxacin and Rhodamine B
- Applying nanocarbon prepared from coal as an anode in lithium-ion batteries
- Improved electrochemical synthesis of Cu–Fe/brass foil alloy followed by combustion for high-efficiency photoelectrodes and hydrogen production in alkaline solutions
- Precipitation of terephthalic acid from post-consumer polyethylene terephthalate waste fractions
- Biosynthesized zinc oxide nanoparticles: Multifunctional potential applications in anticancer, antibacterial, and B. subtilis DNA gyrase docking
- Anticancer and antimicrobial effects of green-synthesized silver nanoparticles using Teucrium polium leaves extract
- Green synthesis of eco-friendly bioplastics from Chlorella and Lithothamnion algae for safe and sustainable solutions for food packaging
- Optimizing coal water slurry concentration via synergistic coal blending and particle size distribution
- Green synthesis of Ag@Cu and silver nanowire using Pterospermum heterophyllum extracts for surface-enhanced Raman scattering
- Green synthesis of copper oxide nanoparticles from Algerian propolis: Exploring biochemical, structural, antimicrobial, and anti-diabetic properties
- Simultaneous quantification of mefenamic acid and paracetamol in fixed-dose combination tablet dosage forms using the green HPTLC method
- Green synthesis of titanium dioxide nanoparticles using green tea (Camellia sinensis) extract: Characteristics and applications
- Pharmaceutical properties for green fabricated ZnO and Ag nanoparticle-mediated Borago officinalis: In silico predications study
- Synthesis and optimization of gemcitabine-loaded nanoparticles by using Box–Behnken design for treating prostate cancer: In vitro characterization and in vivo pharmacokinetic study
- A comparative analysis of single-step and multi-step methods for producing magnetic activated carbon from palm kernel shells: Adsorption of methyl orange dye
- Sustainable green synthesis of silver nanoparticles using walnut septum waste: Characterization and antibacterial properties
- Efficient electrocatalytic reduction of CO2 to CO over Ni/Y diatomic catalysts
- Greener and magnetic Fe3O4 nanoparticles as a recyclable catalyst for Knoevenagel condensation and degradation of industrial Congo red dye
- Recycling of HDPE-giant reed composites: Processability and performance
- Fabrication of antibacterial chitosan/PVA nanofibers co-loaded with curcumin and cefadroxil for wound healing
- Cost-effective one-pot fabrication of iron(iii) oxychloride–iron(iii) oxide nanomaterials for supercapacitor charge storage
- Novel trimetallic (TiO2–MgO–Au) nanoparticles: Biosynthesis, characterization, antimicrobial, and anticancer activities
- Green-synthesized chromium oxide nanoparticles using pomegranate husk extract: Multifunctional bioactivity in antioxidant potential, lipase and amylase inhibition, and cytotoxicity
- Therapeutic potential of sustainable zinc oxide nanoparticles biosynthesized using Tradescantia spathacea aqueous leaf extract
- Chitosan-coated superparamagnetic iron oxide nanoparticles synthesized using Carica papaya bark extract: Evaluation of antioxidant, antibacterial, and anticancer activity of HeLa cervical cancer cells
- Antioxidant potential of peptide fractions from tuna dark muscle protein isolate: A green enzymatic approach
- Clerodendron phlomoides leaf extract-mediated synthesis of selenium nanoparticles for multi-applications
- Optimization of cellulose yield from oil palm trunks with deep eutectic solvents using response surface methodology
- Nitrogen-doped carbon dots from Brahmi (Bacopa monnieri): Metal-free probe for efficient detection of metal pollutants and methylene blue dye degradation
- High energy density pseudocapacitor based on a nanoporous tungsten(VI) oxide iodide/poly(2-amino-1-mercaptobenzene) composite
- Green synthesized Ag–Cu nanocomposites as an improved strategy to fight multidrug-resistant bacteria by inhibition of biofilm formation: In vitro and in silico assessment study
- In vitro evaluation of antibacterial activity and associated cytotoxicity of biogenic silver nanoparticles using various extracts of Tabernaemontana ventricosa
- Fabrication of novel composite materials by impregnating ZnO particles into bacterial cellulose nanofibers for antimicrobial applications
- Solidification floating organic drop for dispersive liquid–liquid microextraction estimation of copper in different water samples
- Kinetics and synthesis of formation of phosphate composites from low-grade phosphorites in the presence of phosphate–siliceous shales and oil sludge
- Removal of minocycline and terramycin by graphene oxide and Cr/Mn base metal–organic framework composites
- Microfluidic preparation of ceramide E liposomes and properties
- Therapeutic potential of Anamirta cocculus (L.) Wight & Arn. leaf aqueous extract-mediated biogenic gold nanoparticles
- Antioxidant-rich Micromeria imbricata leaf extract as a medium for the eco-friendly preparation of silver-doped zinc oxide nanoparticles with antibacterial properties
- Influence of different colors with light regime on Chlorella sp., biomass, pigments, and lipids quantity and quality
- Experimental vibrational analysis of natural fiber composite reinforced with waste materials for energy absorbing applications
- Green synthesis of sea buckthorn-mediated ZnO nanoparticles: Biological applications and acute nanotoxicity studies
- Production of liquid smoke by consecutive electroporation and microwave-assisted pyrolysis of empty fruit bunches
- Synthesis of MPAA based on polyacrylamide and gossypol resin and applications in the encapsulation of ammophos
- Application of iron-based catalysts in the microwave treatment of environmental pollutants
- Enhanced adsorption of Cu(ii) from wastewater using potassium humate-modified coconut husk biochar
- Adsorption of heavy metal ions from water by Fe3O4 nano-particles
- Green synthesis of parsley-derived silver nanoparticles and their enhanced antimicrobial and antioxidant effects against foodborne resistant bacteria
- Unwrapping the phytofabrication of bimetallic silver–selenium nanoparticles: Antibacterial, Anti-virulence (Targeting magA and toxA genes), anti-diabetic, antioxidant, anti-ovarian, and anti-prostate cancer activities
- Review Article
- Sustainable innovations in garlic extraction: A comprehensive review and bibliometric analysis of green extraction methods
- Rapid Communication
- In situ supported rhodium catalyst on mesoporous silica for chemoselective hydrogenation of nitriles to primary amines
- Special Issue: Valorisation of Biowaste to Nanomaterials for Environmental Applications
- Valorization of coconut husk into biochar for lead (Pb2+) adsorption
- Corrigendum
- Corrigendum to “An updated review on carbon nanomaterials: Types, synthesis, functionalization and applications, degradation and toxicity”
Artikel in diesem Heft
- Research Articles
- Optimized green synthesis of silver nanoparticles from guarana seed skin extract with antibacterial potential
- Green adsorbents for water remediation: Removal of Cr(vi) and Ni(ii) using Prosopis glandulosa sawdust and biochar
- Green approach for the synthesis of zinc oxide nanoparticles from methanolic stem extract of Andrographis paniculata and evaluation of antidiabetic activity: In silico GSK-3β analysis
- Development of a green and rapid ethanol-based HPLC assay for aspirin tablets and feasibility evaluation of domestically produced bioethanol in Thailand as a sustainable mobile phase
- A facile biodegradation of polystyrene microplastic by Bacillus subtilis
- Enhanced synthesis of fly ash-derived hydrated sodium silicate adsorbents via low-temperature alkaline hydrothermal treatment for advanced environmental applications
- Impact of metal nanoparticles biosynthesized using camel milk on bacterial growth and copper removal from wastewater
- Preparation of Co/Cr-MOFs for efficient removal of fleroxacin and Rhodamine B
- Applying nanocarbon prepared from coal as an anode in lithium-ion batteries
- Improved electrochemical synthesis of Cu–Fe/brass foil alloy followed by combustion for high-efficiency photoelectrodes and hydrogen production in alkaline solutions
- Precipitation of terephthalic acid from post-consumer polyethylene terephthalate waste fractions
- Biosynthesized zinc oxide nanoparticles: Multifunctional potential applications in anticancer, antibacterial, and B. subtilis DNA gyrase docking
- Anticancer and antimicrobial effects of green-synthesized silver nanoparticles using Teucrium polium leaves extract
- Green synthesis of eco-friendly bioplastics from Chlorella and Lithothamnion algae for safe and sustainable solutions for food packaging
- Optimizing coal water slurry concentration via synergistic coal blending and particle size distribution
- Green synthesis of Ag@Cu and silver nanowire using Pterospermum heterophyllum extracts for surface-enhanced Raman scattering
- Green synthesis of copper oxide nanoparticles from Algerian propolis: Exploring biochemical, structural, antimicrobial, and anti-diabetic properties
- Simultaneous quantification of mefenamic acid and paracetamol in fixed-dose combination tablet dosage forms using the green HPTLC method
- Green synthesis of titanium dioxide nanoparticles using green tea (Camellia sinensis) extract: Characteristics and applications
- Pharmaceutical properties for green fabricated ZnO and Ag nanoparticle-mediated Borago officinalis: In silico predications study
- Synthesis and optimization of gemcitabine-loaded nanoparticles by using Box–Behnken design for treating prostate cancer: In vitro characterization and in vivo pharmacokinetic study
- A comparative analysis of single-step and multi-step methods for producing magnetic activated carbon from palm kernel shells: Adsorption of methyl orange dye
- Sustainable green synthesis of silver nanoparticles using walnut septum waste: Characterization and antibacterial properties
- Efficient electrocatalytic reduction of CO2 to CO over Ni/Y diatomic catalysts
- Greener and magnetic Fe3O4 nanoparticles as a recyclable catalyst for Knoevenagel condensation and degradation of industrial Congo red dye
- Recycling of HDPE-giant reed composites: Processability and performance
- Fabrication of antibacterial chitosan/PVA nanofibers co-loaded with curcumin and cefadroxil for wound healing
- Cost-effective one-pot fabrication of iron(iii) oxychloride–iron(iii) oxide nanomaterials for supercapacitor charge storage
- Novel trimetallic (TiO2–MgO–Au) nanoparticles: Biosynthesis, characterization, antimicrobial, and anticancer activities
- Green-synthesized chromium oxide nanoparticles using pomegranate husk extract: Multifunctional bioactivity in antioxidant potential, lipase and amylase inhibition, and cytotoxicity
- Therapeutic potential of sustainable zinc oxide nanoparticles biosynthesized using Tradescantia spathacea aqueous leaf extract
- Chitosan-coated superparamagnetic iron oxide nanoparticles synthesized using Carica papaya bark extract: Evaluation of antioxidant, antibacterial, and anticancer activity of HeLa cervical cancer cells
- Antioxidant potential of peptide fractions from tuna dark muscle protein isolate: A green enzymatic approach
- Clerodendron phlomoides leaf extract-mediated synthesis of selenium nanoparticles for multi-applications
- Optimization of cellulose yield from oil palm trunks with deep eutectic solvents using response surface methodology
- Nitrogen-doped carbon dots from Brahmi (Bacopa monnieri): Metal-free probe for efficient detection of metal pollutants and methylene blue dye degradation
- High energy density pseudocapacitor based on a nanoporous tungsten(VI) oxide iodide/poly(2-amino-1-mercaptobenzene) composite
- Green synthesized Ag–Cu nanocomposites as an improved strategy to fight multidrug-resistant bacteria by inhibition of biofilm formation: In vitro and in silico assessment study
- In vitro evaluation of antibacterial activity and associated cytotoxicity of biogenic silver nanoparticles using various extracts of Tabernaemontana ventricosa
- Fabrication of novel composite materials by impregnating ZnO particles into bacterial cellulose nanofibers for antimicrobial applications
- Solidification floating organic drop for dispersive liquid–liquid microextraction estimation of copper in different water samples
- Kinetics and synthesis of formation of phosphate composites from low-grade phosphorites in the presence of phosphate–siliceous shales and oil sludge
- Removal of minocycline and terramycin by graphene oxide and Cr/Mn base metal–organic framework composites
- Microfluidic preparation of ceramide E liposomes and properties
- Therapeutic potential of Anamirta cocculus (L.) Wight & Arn. leaf aqueous extract-mediated biogenic gold nanoparticles
- Antioxidant-rich Micromeria imbricata leaf extract as a medium for the eco-friendly preparation of silver-doped zinc oxide nanoparticles with antibacterial properties
- Influence of different colors with light regime on Chlorella sp., biomass, pigments, and lipids quantity and quality
- Experimental vibrational analysis of natural fiber composite reinforced with waste materials for energy absorbing applications
- Green synthesis of sea buckthorn-mediated ZnO nanoparticles: Biological applications and acute nanotoxicity studies
- Production of liquid smoke by consecutive electroporation and microwave-assisted pyrolysis of empty fruit bunches
- Synthesis of MPAA based on polyacrylamide and gossypol resin and applications in the encapsulation of ammophos
- Application of iron-based catalysts in the microwave treatment of environmental pollutants
- Enhanced adsorption of Cu(ii) from wastewater using potassium humate-modified coconut husk biochar
- Adsorption of heavy metal ions from water by Fe3O4 nano-particles
- Green synthesis of parsley-derived silver nanoparticles and their enhanced antimicrobial and antioxidant effects against foodborne resistant bacteria
- Unwrapping the phytofabrication of bimetallic silver–selenium nanoparticles: Antibacterial, Anti-virulence (Targeting magA and toxA genes), anti-diabetic, antioxidant, anti-ovarian, and anti-prostate cancer activities
- Review Article
- Sustainable innovations in garlic extraction: A comprehensive review and bibliometric analysis of green extraction methods
- Rapid Communication
- In situ supported rhodium catalyst on mesoporous silica for chemoselective hydrogenation of nitriles to primary amines
- Special Issue: Valorisation of Biowaste to Nanomaterials for Environmental Applications
- Valorization of coconut husk into biochar for lead (Pb2+) adsorption
- Corrigendum
- Corrigendum to “An updated review on carbon nanomaterials: Types, synthesis, functionalization and applications, degradation and toxicity”

